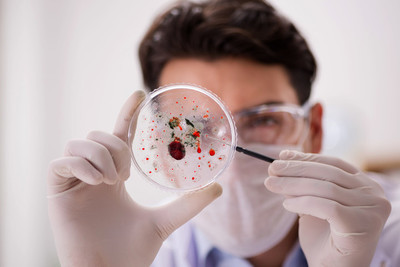

在妊娠结局中,起决定作用的是女性年龄,这一点是众人所认可的。随着女性年龄的增长,妊娠率、活产率逐渐下降,高龄女性妊娠期并发症的风险也明显增加了。但高龄男性这一块,受到的关注没有高龄女性那么大。
高龄男性也会遭遇生育困境。这一点需要引起足够的重视,在不孕门诊的接待中,高龄不孕夫妇多半会认为是女方的问题,其实高龄男性对妊娠结局的影响也要引起关注。
研究发现,当女性年龄在30岁时,男性伴侣年龄在40岁~42岁做“试管婴儿”的成功率要比年龄在30岁~35岁低46%。
可见除了女性年龄大、卵巢功能衰退、卵子质量下降影响生育力外,高龄男性的精虫质量下降,也会直接影响胚胎质量、着床能力、怀孕率,以及流产率。建议高龄夫妻接受试管婴儿疗程期间,更应相互扶持鼓励,多点耐心,等待好「孕」的到来。




